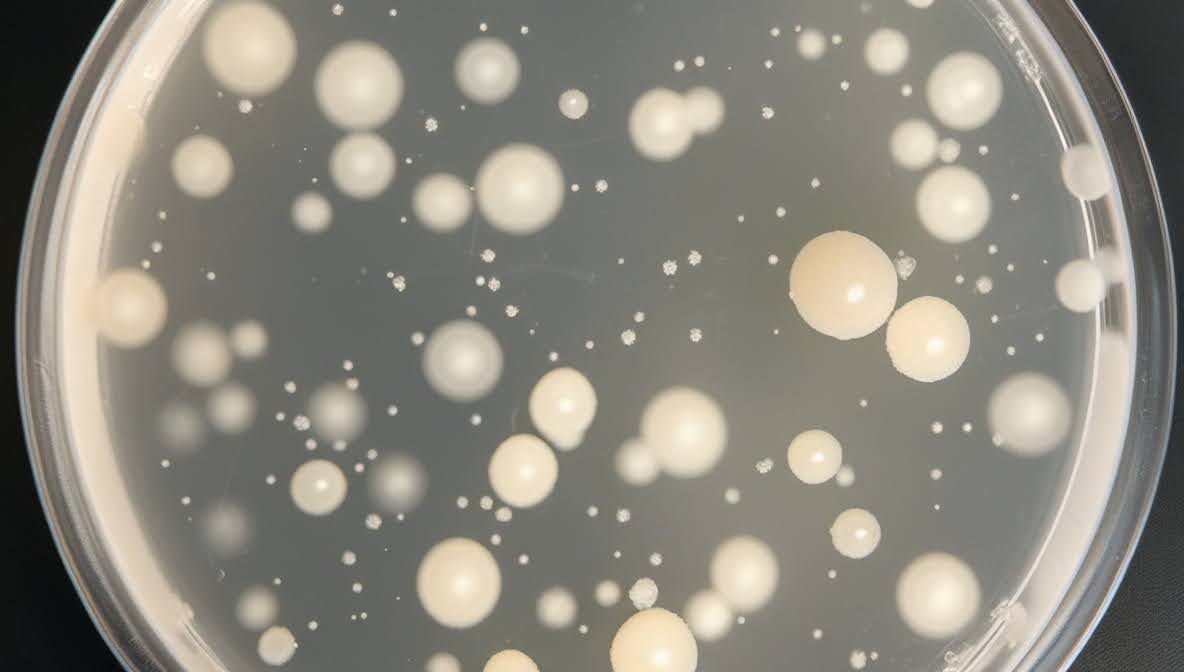
ナノマテリアル判定

研究者/技術者のための
新しいAI画像分析
「画像の面倒な前処理」「ツールではうまくいかない画像の手動解析」
もはや当たり前になっていた悩みはGeXeLですべて解決。
簡単・リーズナブル・高精度の全てを叶える画像解析がここにあります。
AI画像解析で可能性を広げる
当社のAI画像解析は、AIならではの、大量の画像データを高速かつ正確に処理できる利点を活かし多岐にわたる分野で活躍しています。
人の手だけでは実現が困難だった様々な技術やサービスが、いま続々と誕生しています。





「画像の面倒な前処理」「ツールではうまくいかない画像の手動解析」
もはや当たり前になっていた悩みはGeXeLですべて解決。
簡単・リーズナブル・高精度の全てを叶える画像解析がここにあります。
当社のAI画像解析は、AIならではの、大量の画像データを高速かつ正確に処理できる利点を活かし多岐にわたる分野で活躍しています。
人の手だけでは実現が困難だった様々な技術やサービスが、いま続々と誕生しています。